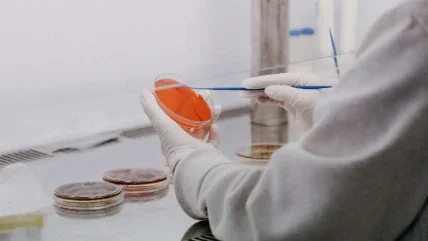

Biofortuna Limited, the specialist laboratory services and CDMO, has completed the acquisition of Cryoniss Ltd, underlining its commitment to support life-changing research and development across the global biotech and life sciences sector.
The acquisition of Cryoniss brings expertise and infrastructure in temperature-controlled biological sample storage, strengthening Biofortuna’s existing stability storage capability and accelerating the growth of its controlled-environment storage offering.
Cryoniss specialise in the provision of sample storage and bio-repository solutions at ultra-low and cryogenic conditions for long term storage of biological samples to the global life sciences sector, research institutions and governmental agencies. Applications include academic research, therapeutic drug discovery and diagnostic test development.
Dr Nick Ash, CEO of Biofortuna said: “Cryoniss is a perfect fit with our existing controlled- environment storage and cell line services business. With customers increasingly looking for single site provision of sample storage and analytical services, Biofortuna is now perfectly positioned to deliver a fully integrated, end-to-end service. I am delighted to welcome the Cryoniss team to Biofortuna.”
Sonia Houghton, CEO of Cryoniss added: “The acquisition by Biofortuna presents a host of new opportunities. It will allow us to showcase our expert temperature-controlled services to a much wider audience across the life sciences and biotech sectors, and enable our customers to access our highly accredited services quickly and efficiently.”






